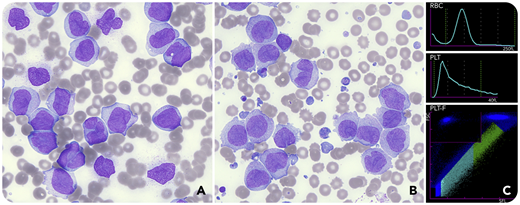
A 46-year-old woman presented acutely unwell with high blast count acute monoblastic leukemia (AML; white cell count, 321.6 × 109/L; hemoglobin, 89 g/L; platelet count, 56 × 109/L). At 6 hours post cytoreductive therapy, she developed tumor lysis syndrome, as defined by the Cairo-Bishop criteria, requiring management with rasbirucase and renal replacement therapy. A full blood count at this point showed an unexpected increase in the platelet count to 375 × 109/L using the impedance method (PLT-I) and 360 × 109/L using the fluorescent platelet channel (PLT-F) on the Sysmex XN-20 (Kobe, Japan). Her blood film showed new frequent small basophilic bodies, some containing pyknotic nuclei (panel A, before treatment; panel B, after treatment; Wright stain, 40× objective; total magnification ×400). These leukemic fragments developed after therapy and were indistinguishable from platelets not only by PLT-I but also by PLT-F (panel C; PLT-I histogram and PLT-F scattergram). The patient received twice daily prophylactic platelet transfusions, as an accurate platelet count could not be obtained by automated or manual means. Unfortunately, despite this, she suffered intracranial hemorrhages and died 72 hours after presentation.

A 46-year-old woman presented acutely unwell with high blast count acute monoblastic leukemia (AML; white cell count, 321.6 × 109/L; hemoglobin, 89 g/L; platelet count, 56 × 109/L). At 6 hours post cytoreductive therapy, she developed tumor lysis syndrome, as defined by the Cairo-Bishop criteria, requiring management with rasbirucase and renal replacement therapy. A full blood count at this point showed an unexpected increase in the platelet count to 375 × 109/L using the impedance method (PLT-I) and 360 × 109/L using the fluorescent platelet channel (PLT-F) on the Sysmex XN-20 (Kobe, Japan). Her blood film showed new frequent small basophilic bodies, some containing pyknotic nuclei (panel A, before treatment; panel B, after treatment; Wright stain, 40× objective; total magnification ×400). These leukemic fragments developed after therapy and were indistinguishable from platelets not only by PLT-I but also by PLT-F (panel C; PLT-I histogram and PLT-F scattergram). The patient received twice daily prophylactic platelet transfusions, as an accurate platelet count could not be obtained by automated or manual means. Unfortunately, despite this, she suffered intracranial hemorrhages and died 72 hours after presentation.
This case demonstrates that even with modern hematology analyzers, white cell fragmentation may still interfere with platelet counts. Review of the blood film for spurious indices remains a cornerstone of good hematology laboratory practice.
A 46-year-old woman presented acutely unwell with high blast count acute monoblastic leukemia (AML; white cell count, 321.6 × 109/L; hemoglobin, 89 g/L; platelet count, 56 × 109/L). At 6 hours post cytoreductive therapy, she developed tumor lysis syndrome, as defined by the Cairo-Bishop criteria, requiring management with rasbirucase and renal replacement therapy. A full blood count at this point showed an unexpected increase in the platelet count to 375 × 109/L using the impedance method (PLT-I) and 360 × 109/L using the fluorescent platelet channel (PLT-F) on the Sysmex XN-20 (Kobe, Japan). Her blood film showed new frequent small basophilic bodies, some containing pyknotic nuclei (panel A, before treatment; panel B, after treatment; Wright stain, 40× objective; total magnification ×400). These leukemic fragments developed after therapy and were indistinguishable from platelets not only by PLT-I but also by PLT-F (panel C; PLT-I histogram and PLT-F scattergram). The patient received twice daily prophylactic platelet transfusions, as an accurate platelet count could not be obtained by automated or manual means. Unfortunately, despite this, she suffered intracranial hemorrhages and died 72 hours after presentation.
This case demonstrates that even with modern hematology analyzers, white cell fragmentation may still interfere with platelet counts. Review of the blood film for spurious indices remains a cornerstone of good hematology laboratory practice.
For additional images, visit the ASH Image Bank, a reference and teaching tool that is continually updated with new atlas and case study images. For more information, visit http://imagebank.hematology.org.